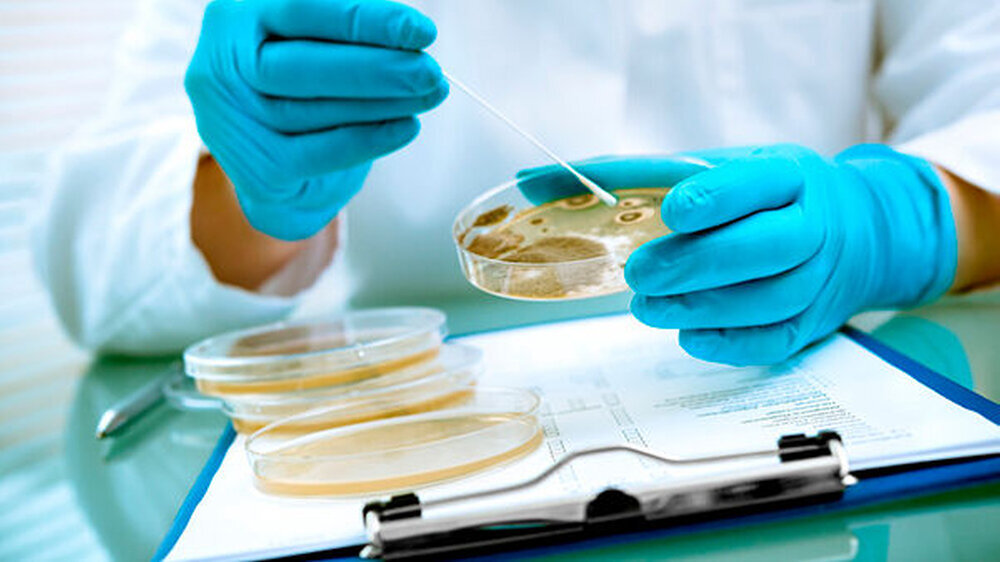

Resistenz gegen Notfall-Antibiotikum seit 2012
Colistin gilt als Reserve-Antibiotikum und wird bei Patienten eingesetzt, bei denen gängige Präparate nicht mehr anschlagen.
In Münster konnte jetzt erstmals das Colistin-resistente mcr-1-Gen bei einer Patientenprobe aus dem Jahr 2012 nachgewiesen werden. Der bisher älteste Nachweis einer Colistin-Resistenz bei einem Menschen in Deutschland war 2014.
Die Mikrobiologen des Universitätsklinikum Münster (UKM) untersuchten gezielt vier noch vorhandene Isolate auf das Gen, das insbesondere Darmbakterien wie beispielsweise das Escherichia-Coli-Bakterium gegen Colistin resistent macht. „Wir konnten das mcr-1 Gen in jeweils einer Probe aus dem Jahr 2012 und 2014 nachweisen“, sagt Dr. Jörg Wüllenweber, Oberarzt am Institut für Medizinische Mikrobiologie des UKM. „Diese Funde belegen, dass das Gen in Bakterien isoliert vom Menschen schon mindestens seit 2012 in Deutschland vorkommt.“
Resistenz übertragbar? Forscher sind alarmiert!
Bisher waren lediglich vier Fälle in Deutschland bekannt: Drei wurden bei Schweinen nachgewiesen, das früheste 2010, und eines beim Menschen aus einer Probe von 2014. In den USA wurde zudem im Mai erstmals ein Fall einer 49 Jahre alten Patientin bekannt, die routinemäßig auf das Ansprechen des Reserveantibiotikums Colistin beziehungsweise das mcr-1-Gen getestet wurde.
Bei den beiden in Münster positiv getesteten Isolaten handelt es sich um Keime, die zwar einige weitere Resistenzen aufweisen, aber – im Gegensatz zum Fall aus den USA – nicht komplett resistent sind. „Dennoch sind wir alarmiert, da diese Art der Resistenz möglicherweise übertragbar ist“, so Wüllenweber. In der Folge wäre bei einer zunehmenden Anzahl von Infektionen die Behandlung mit dem Reserve-Antibiotikum Colistin nicht mehr möglich. „Es muss weiter erforscht werden, ob sich die Colistin-resistenten E.coli-Stämme in Deutschland ausbreiten und eine Übertragung auch auf andere Darmkeime oder zwischen Tier und Mensch auftritt", erläutert Wüllenweber.